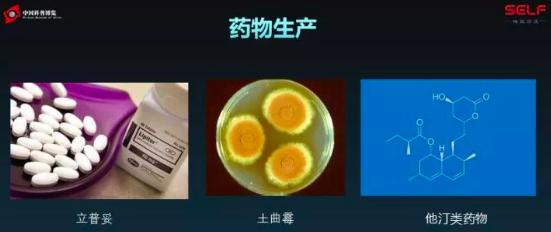
塑料大概多少年才能在自然界降解,塑料究竟可以降解吗

据《每日邮报》报道,奥地利科学家发表研究证实了塑料已经进入人类体内,他们推测每人每年吃下约7.3万片微塑料。一个非常残酷的事实是塑料的降解大概需要300年,而人类发明第一块塑料是在1862年,意味着什么?这意味着人类发明的第一块塑料想要降解完还需要150年…

出品:"SELF格致论道讲坛"公众号(ID:SELFtalks)以下内容为Bluepha首席技术官张浩千演讲实录:
大家好,先说说我自己,我本科在北大生命科学学院就读,博士在北大物理学院,所以这种交叉学科的背景使得我会以一个工程师的视角来看待生命科学的问题。

先给大家看一张图片,这是什么呀?是土豆,还是一个发霉的土豆,上面的霉菌可以合成一种化学物质,这种化学物质是一种特效的抗生素。其实可能在座的很多朋友们都知道,目前为止我们人类所有成功商业化的抗生素已经都能够被细菌耐药了。也就是说,假如有一种细菌具有了所有的耐药性,又产生了大规模的爆发,我们是毫无反抗之力的。这种链霉菌上发现的新型抗生素,其实对于解决或者缓解这个问题有非常大的帮助。

再给大家看一张图片,这张图片是在深海海底发现的一种厌氧细菌。这个细菌的细胞膜里有一种化学物质,这个化学物质长得特别像梯子,尤其它的右半部分,它的名字叫梯烷(Ladderane)。它是一种非常非常高能的化学物质,可以用做火箭燃料。

再给大家看一个有趣的东西,左边这张图片是一个细菌,这个细菌它有一个指南针,是真的指南针。这是四氧化三铁颗粒排成一个针状结构,可以根据磁场指导细胞去游动。这个指南针的组成是四氧化三铁颗粒,是由细菌自己合成的,它是一个大小非常均一,一般在几纳米到十几纳米之间的一个纳米物质。迄今为止,我们人类最精细的制造技术也没有办法造出形状这么规则、大小均一的纳米物质,如果我们在纳米上想用这个东西,只能在细菌上拿到。
最后给大家举的例子可能有些朋友已经非常了解了,就是固氮。豆科植物的根部可以跟一些细菌共生,细菌把大气里面的氮气变成氨,作为营养物质供给植物。植物反馈给一些营养物质,两拨生物相互之间共生,还有一些细菌不需要豆科植物自己就能固氮。可以想像,如果我们要是能够把这些固氮功能转移到水稻或者小麦身上,那么我们的粮食生产第一可以摆脱化肥了,第二我们也可以避免化工厂带来的很多污染。
刚才给大家举的是一些很有趣的生物功能,但是大家心里面肯定有一个问题,这些生物功能到底能不能够应用于我们真正的生活中?我想告诉大家的是,其实我们是有一定的技术基础的,这里给大家展示几个例子,就是展现我们技术基础的例子。
第一个就是氨基酸。我们日常使用的味精是一种氨基酸,还有很多其他药品和食物里面都需要添加各种各样的氨基酸。构成细胞的21种氨基酸里面,有20种目前为止都是由图中这三种微生物来合成的。还有一种当然是化工合成,但是也是可以用生物做到的,只是成本有点贵,理论上来说21种都可以用生物来做。
还有就是我们现在吃的药,这些药物里面有1/3都是由细菌或者真菌这种微生物来合成。这是立普妥,年龄大一点的同志会比较了解,因为它是治疗心血管疾病的特效药,是由土曲霉合成的。

大学生朋友就更了解了,这是点外卖的时候会配送一些很脆的、稍微使点劲就容易断的刀和叉。这些刀叉也是微生物合成的,大家可能会觉得很神奇,这是怎么做的呢?玉米淀粉被微生物变成了乳酸,再经过适当的化工聚合,最终把它变成了我们想要的这种塑料,现在外卖里大量的刀叉都是拿微生物来制造的。
除了刚才给大家举的例子,还有一些例子可能大家更熟悉了,啤酒、酸奶、抗生素、胰岛素。这里面可能有两个例子大家比较震撼,一个是玻尿酸,女孩子们美容用的玻尿酸其实也是微生物合成的。还有一个是椰果,大家点的奶茶里的椰果其实不是从椰子刮下来的,是微生物木醋杆菌合成的。
所以如果把细胞看成工厂的话,其实它完美地契合我们对于工厂的定义,它是把原料变成我们想要的产品。除了这一点它还有自己的特性,第一,因为生物自己的生长和合成是不需要人管的,它是无人值守、全自动化的工厂;第二,因为生物是可以自我修复的,所以当它遇到不好的环境,受到不好的处理之后还可以自我修复;第三点是工厂能自我复制,每30分钟就能复制自己一次。
当然这个有好有坏,好的话复制这个工厂很便宜,不好就是知识产权保护不好的话,别人复制你的工厂也很容易。所以这是一个现在生物技术产业界大家面临的问题;第四点是它尺寸很小,所以可以把它局限在一个反应器里面,这样所有的废水、废气、废物都可以收集起来得到有效控制。
跟大家讲了我们现在关于细胞工厂的技术基础,我一开始举的几个例子能不能得到很好的应用呢?其实还是有点欠缺,原因在于这四种生物功能背后所涉及的通常都是几十到上百个基因之间的相互作用,而我刚才给大家举的几个是现在已经在我们生活中得到很好应用的案例,其实通常只涉及一到几个基因。
大家可以想一下,如果是你带着几十个甚至上百个人来干活,你还需要一个很复杂的协调和组织呢,更何况在细胞里面几十上百个基因一起合作,这背后需要写的程序是非常复杂的。

给大家举一个更形象的例子,左边这样图片是大肠杆菌,它在我们生活中无处不在。这个细菌可以看作是一个直径0.5微米、长度2微米的圆柱体。在这么小的空间内,它有400万的碱基对,更重要的是它有4400个基因在同时表达着,而且同时在发生不少于3000个化学反应。如果我们把这4400个基因中每个基因看做一个点,基因与基因之间如果相互作用就连成一条线,那就是右边的图。可以看到即便在这么小的空间,这么简单的一个生物,它内部的相互作用也是非常复杂的。

就是因为这种生物系统的复杂性,就带来了一个非常棘手的问题。可能学电子工程或者计算机的同学会知道,电子工程里面有一个定律叫做“摩尔定律(Moore’s Law)”。什么叫“摩尔定律”?大概意思是说CPU的计算能力每隔一段时间,通常是18个月就会翻一倍,或者是芯片价格就降一倍,总的来说每18个月就厉害一倍。但是生物不是这样,举个例子,咱们生物医药呈现出“反摩尔定律(Eroom’s Law)”。就是说同样十亿美元,在1950年的时候十亿美元能开发出十几个新药,到2010年连一种都开发不出来,所以英文“摩尔”也是反过来写的。
这就揭示我们技术现在遇到问题和瓶颈了,我们投入相同的资源得到的产出越来越少,所以我们必须要换技术路线了,要进行一种技术革新。根据我们以往解决复杂问题的经验,我们有没有可以借鉴的呢?其实是有,在座的每位都有手机,手机里一张芯片有上亿个“逻辑门”,处理的功能这么复杂,我们是怎么样应对这种复杂度的呢?
其实很简单,就是工程化原则。我们现在不管一个系统多复杂,我们都能按照从“元件-器件-模块-系统”的方式自下而上的组装出来。这里有两个工程化原则非常关键,第一是模块化,模块化的作用是什么?让系统的组份与组份、元件与元件之间越独立越好,这样就能自下而上的拼装起来,组装预测性特别高。
还有一个原则是标准化。标准化就是让每个人在这个工程中所做出的努力都能被其他人所用,比如有人造螺丝、有人造螺母,如果大家按照一个标准来,造螺丝和造螺母的人就能组合起来,就能把一个复杂的事情拆解成一个简单的工作,并且分配给每个人,最终每个人做出的东西还能组装在一起。
正是因为这种工程化原则的使用,使得我们人类可以做出非常复杂的东西,例如超级计算机。所以“摩尔定律”就由此不断地产生新的突破,并且一直得到保持。

那我们的细胞呢?我们的生物系统,其实我们如果以另外的视角来看,它也是一种工程系统。它可以看作基因,也就是说DNA材料。DNA作为材料以生物大分子之间的相互作用的形式,比如说它先组装成一些代谢通路、调控通路,这些通路组装成细胞,这些细胞组装成组织,最终形成一些复杂的个体,也可以看成自上而下的工程系统。
正如我们的CPU,它不是从路边随便捡来的是石头就能加工成CPU,虽然说它也是硅,但是这个硅是精炼出来的。我们假如说对生物系统进行工程化的话,我们的材料也不是随便拿来的。每个生物都有自己的基因,我们把这些基因都拿来,去掉我们不想要的功能,保留最基本、最简单的功能,然后我们把它进行一些标准化、模块化的加工,最终就可以得到生物的乐高积木,就是一列一列的基因片段,它们相互之间是绝缘化的,而且接口是标准化的,那么我们可以把它叫做“基因元件”。

这个“基因元件”就可以让我们以拼乐高积木的形式、自下而上地拼装出一些复杂的生物系统,我们把它叫做“基因计算机”。因为它有感受器,可以感受细胞内外的各种环境,它也可以进行信息处理,把一些复杂的信号进行内部处理之后,最终呈现出各种各样的生物功能输出,我们就把它叫做“基因计算机”。

这种能力使得我们可以在微生物里面,每个微生物细胞里面都可以写一个微型的“基因计算机”,从而执行我们想让它们执行的功能。比如可以用于生物制造,还可以把它放到肠道里面侦测消化道里的癌症和炎症;还可以用于土壤,用来去除重金属污染和化工型污染;还可以用于环境,废水处理、污水处理,甚至可以从废水里冶炼出贵重金属,这都是微生物可以做到的。
在这里举一个非常有趣的例子,这也是我博士期间在做的事情,以及博士毕业之后和清华的老师同学一起创业的事情。大家身边很多物件都是塑料做的,这些塑料都是从石油里面提取出来的。一个非常残酷的事实是塑料的降解大概需要300年,而人类发明第一块塑料是在1862年,意味着什么?这意味着人类发明的第一块塑料想要降解完还需要150年。

这张图片相信在座的各位其实并不陌生,因为我们在生活中经常会看到动物因为吞食塑料而死、植物因为塑料添加剂的毒性而枯萎的现象。我在博士期间,跟清华的老师、同学做了一个非常有趣的事情,去全国各地找一些有趣的微生物。

我们在*疆新**的艾丁湖,距离我家乡没多远,我们发现一株非常有意思的微生物。左上角的图是一个平板,是一个培养基的平板,上面每个白点都是一个细菌的菌落。我们发现有些菌落非常有趣,它是白色的,特别白。在显微镜下放大了看,它里面也有一些白色颗粒,这些白色颗粒经过鉴定是什么东西呢?其实是生物可降解的塑料,叫做“聚羟基烷酸酯(PHA)”。理论上它可以替代我们现在生活中绝大部分石油基的塑料,但是它有什么问题?价格太贵了,它是现在塑料的5-10倍。虽然大家有环保理想,但在钱包在现实面前还是没办法,做不出更理想的选择。

怎么让大家做出更理想的选择呢?我们这个“基因计算机”或者我们在细胞里编程序这件事就有用了,我们可以在细胞里编程序,让细胞把它生理代谢活动的所有能量,都用于生产聚羟基烷酸酯,简称PHA。比如我们做的第一代,细胞里就有大块白色颗粒了,我们还可以做第二代,细胞已经很“胖”了,还可以做第三代,细胞已经是“超级大胖子”了,里面90%的质量差不多都是PHA了。
我们经过两到三年的实验和工业化尝试,现在已经成功的在山东实现了工业化生产。我们生产PHA使用的是可以再生的粮食资源,比如咱们国家其实存粮,陈旧的粮食已经很多了,数以亿吨计,要不就放着烂了,还不如利用起来。与此同时我们生产出的生物塑料PHA是百分之百生物可降解,理论上不加特殊物质,埋在土里半年到一年就完全降解了,变成营养物质被微生物利用了。所以它是取之于自然,而最终又回馈于自然的东西。

最后给大家看一个更形象的案例,我们在清华校园里做的一个实验。大家先别好奇,为什么我一个北大人拿清华校园做实验。我们在清华校园挖了一个坑,把两个塑料片埋到土里面,半年以后再把塑料片挖出来,就是我们现在看到的效果。左图就是PHA的塑料片,半年以后千疮百孔,细菌在上面快乐地生长着。而聚乙烯塑料片完好无损,300年以后才能降解。
我想告诉大家的是,我们现在生活中遇到的绝大部分的塑料其实都是非常难以降解的。300年是一个非常保守的数字,而且是在各种环境都很良好的情况下,生物才能利用起来。我们这个PHA是很有希望能够替代现在已有的石油基塑料的,并且现在我们已经把成本做到了传统石油基塑料的2-3倍。
很多人在做科研的时候都会关注一点,就是科技的创新性如何。但是我更关注的一点是,科技这个东西怎么样更好的应用于我们的生活。因为我们生活中很多时候遇到的问题不仅仅是科学问题,作为科学家我们也不能关心的仅仅是科学,我们要综合运用金融、教育、人文、管理等各个方面的力量把它们综合在一起,为我们的未来创造一个更加绿色、智能、环保的世界。
谢谢大家!
“SELF格致论道”讲坛是中国科学院全力推出的科学文化讲坛,致力于精英思想的跨界传播,由中国科学院计算机网络信息中心和中国科学院科学传播局联合主办,中国科普博览承办。SELF是Science, Education, Life, Future的缩写,旨在以“格物致知”的精神探讨科技、教育、生活、未来的发展。关注微信公众号SELFtalks获取更多信息。
本文出品自“SELF格致论道讲坛”公众号(SELFtalks),转载请注明公众号出处,未经授权不得转载。